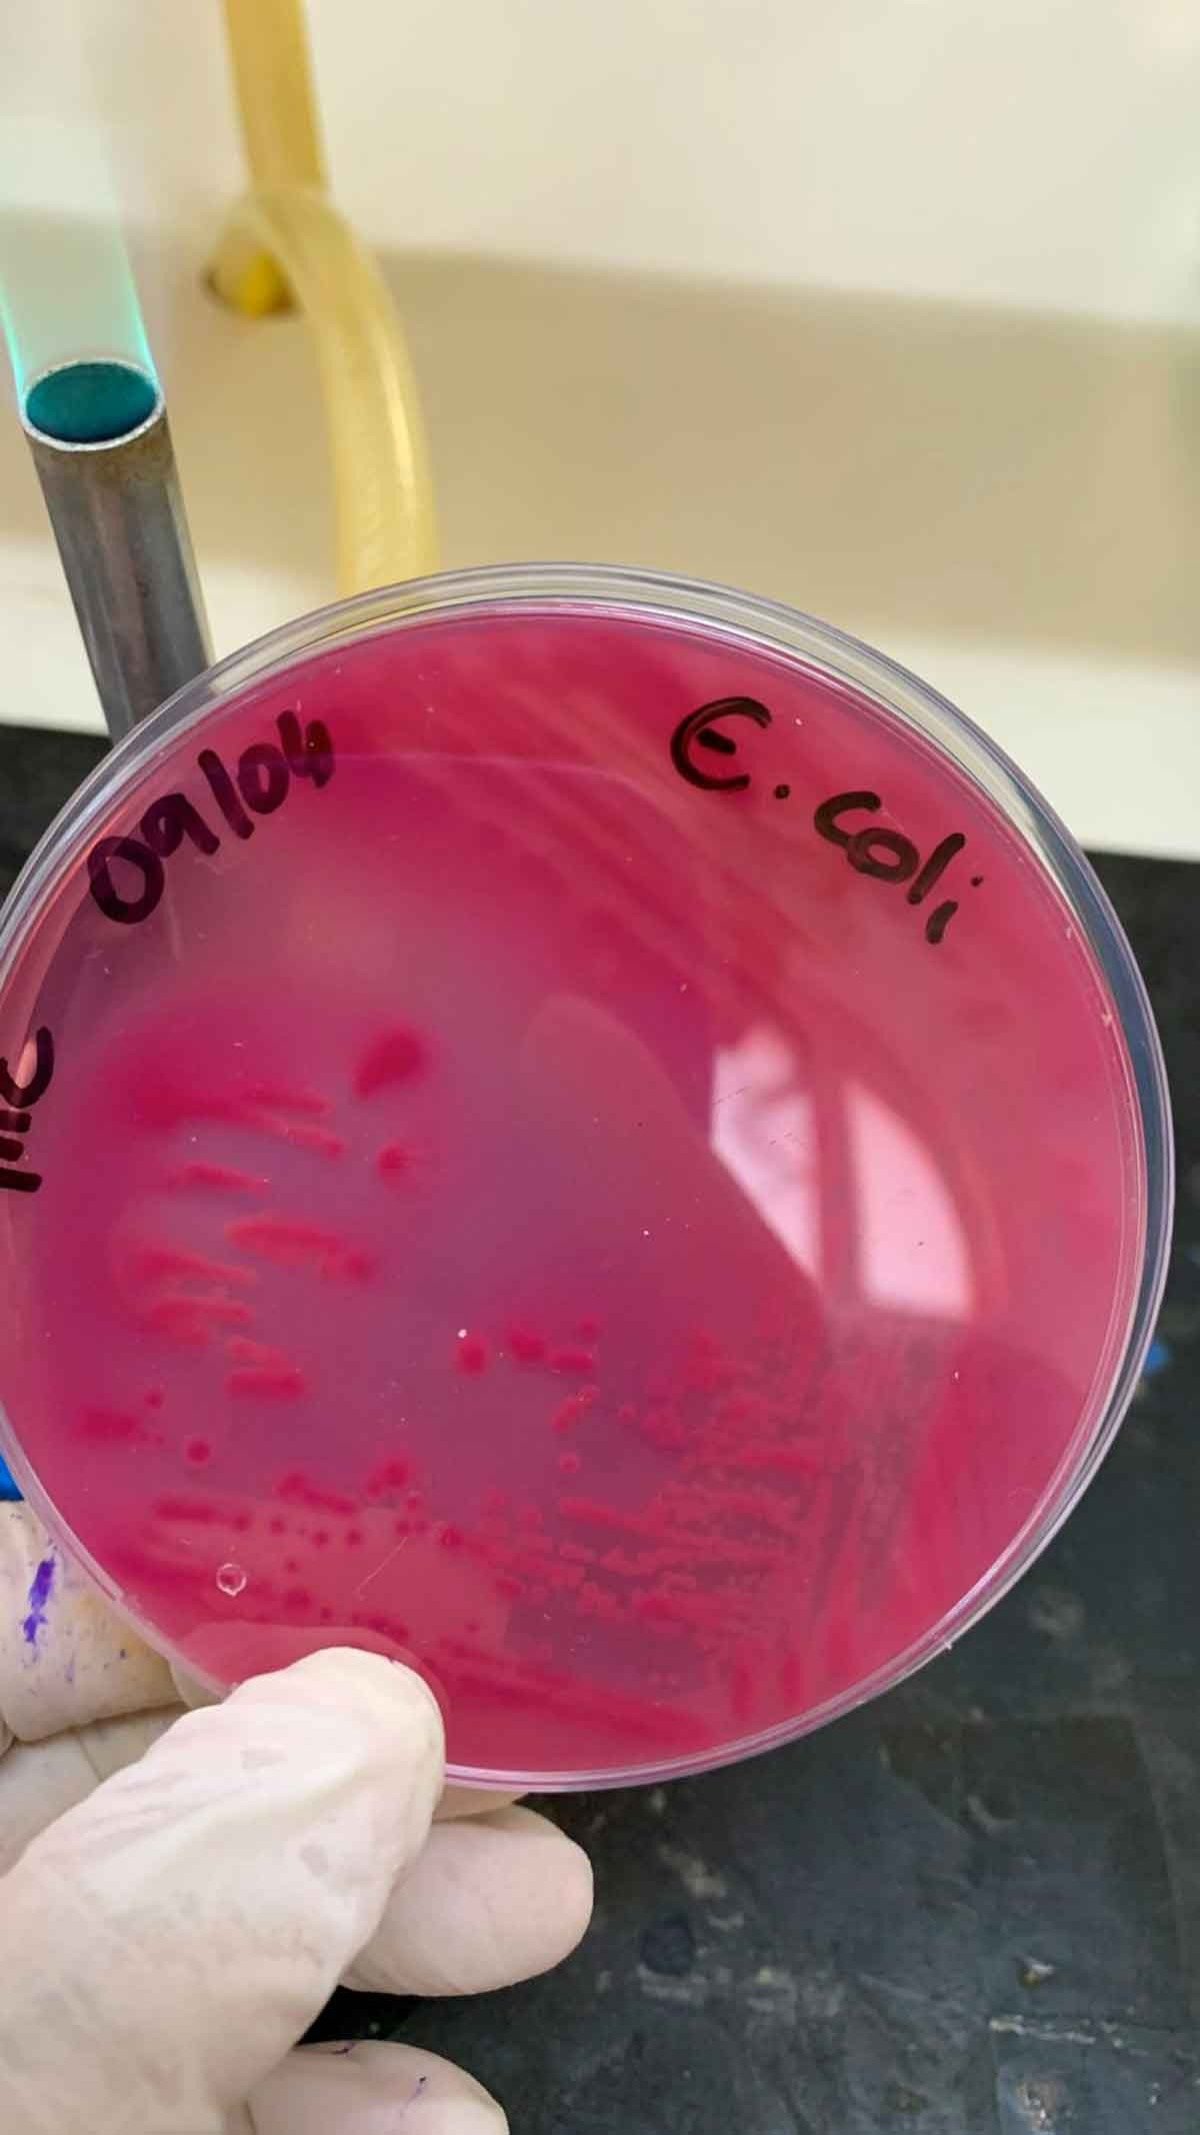
O estudo aponta ind&iacute;cios da bact&eacute;ria Escherichia coli em diferentes esp&eacute;cies

Estudo identifica os riscos do alto uso de remédios em animais
Análises em desenvolvimento pela UFLA indicam que o emprego elevado de antimicrobianos pode causar resistências e afetar as criações
compartilhe
SIGA

Uma pesquisa em desenvolvimento na Universidade Federal de Lavras (UFLA) revelou uma significativa incidência de cepas resistentes a antimicrobianos – antibióticos, antivirais, antifúngicos e antiparasitários – de uma bactéria comum no intestino de pessoas e animais que se mostram resistentes a antimicrobianos. O estudo ainda aponta indícios de circulação dessa bactéria, a Escherichia coli, entre diferentes espécies.
Mesmo presente no organismo dos mamíferos, geralmente a E. coli é inofensiva à saúde. No entanto, cepas patogênicas podem causar infecções sérias, que podem levar à morte muito rápido. De acordo com a professora Elaine Dorneles, coordenadora do projeto, este micro-organismo tem uma boa capacidade de interagir com outras bactérias e buscar nelas material genético que vai permitir, por exemplo, ser resistente a um antimicrobiano, ou produzir uma toxina que causa diarreia ou necrose do intestino, ou ainda produzir um determinado mecanismo que permite que ela faça uma melhor adesão ao intestino e cause infecção.
A pesquisadora explica que a resistência de bactérias a antimicrobianos é um problema que deve ser enfrentado: “O uso inadequado de antimicrobiano leva à seleção de bactérias resistentes. O grande problema é que novas drogas não estão surgindo na mesma velocidade em que as velhas se mostram menos eficazes. A indústria farmacêutica não investe na produção de novos fármacos com a mesma velocidade com que a gente usa indiscriminadamente os antimicrobianos que temos.”

“O uso inadequado de antimicrobiano leva à seleção de bactérias resistentes. O grande problema é que novas drogas não estão surgindo na mesma velocidade em que as velhas se mostram menos eficazes” -
Elaine Dorneles, Professora e coordenadora do projeto
CONTROLE MAIOR
Assim, ela recomenda, em pessoas e animais, que o tratamento prescrito pelo médico ou pelo veterinário – tomar o antibiótico até o final e nos horários corretos – seja seguido à risca e apenas quando necessário, para evitar a resistência. “O grande salto da expectativa de vida da população humana aconteceu após a descoberta dos antimicrobianos, lá nos anos de 1920. A partir disso a gente já não morre mais por qualquer infecção. Mas, estamos usando uma arma tão importante de maneira pouco racional, pouco responsável.”
Por isso, Elaine defende um controle mais rígido da venda e prescrição desses medicamentos também no meio veterinário. Ela disse que esse entendimento já está em curso no Ministério da Agricultura e Pecuária (Mapa), mas que hoje isso não existe. “Eu considero essa etapa fundamental. Veja o que aconteceu na população humana. Alguns anos atrás, ainda me recordo, a gente também não precisava de receita para comprar antibiótico. A partir do maior controle, o uso diminui, junto com a pressão de seleção, e ganhamos um maior fôlego para usar os antibióticos por mais tempo”, disse.
CIRCULAÇÃO ENTRE ESPÉCIES
Outro ponto identificado pela pesquisa é a circulação da mesma bactéria entre animais de produção, de companhia e a população humana. Esta constatação é feita por meio da análise genética a partir de amostras isoladas de cadelas com infecção uterina, de humanos com infecção urinária, de animais silvestres, de vacas com mastite e de bezerros com diarreia.
“Resultados preliminares indicam que as bactérias estão circulando para além da espécie que a gente isolou. A gente quer entender qual é o potencial que essas amostras têm de causar doenças graves. O que essa bactéria tem de arsenal para causar doença. Estamos procurando fatores nessas bactérias que aumentam seu potencial de causar doença e também, principalmente, a resistência a drogas”, disse a professora.
Elaine relata que sua equipe de pesquisa já conseguiu sequenciar o DNA de todas as bactérias isoladas e agora está comparando os genomas. “Já encontramos bactérias isoladas de pacientes humanos hospitalizados que têm provável origem animal.” É preciso conscientizar a população para consumir somente alimentos que tenham um selo de inspeção. Mesmo os produtos artesanais certificados de qualidade, como o Selo ARTE do Queijo Minas Artesanal.
“Um contato mais íntimo, associado a uma menor higiene, pode favorecer essa disseminação da bactéria. Não advogando contra ter pets ou ter pets em casa. Mas, o compartilhamento, por exemplo, de camas ou outros locais podem favorecer essa circulação porque eu posso ter bactérias no intestino que vão contaminar uma almofada, um sofá, a mão, e aí, na hora que você leva isso à boca, você pode, sim, ter uma infecção. Isso é muito mais perigoso para crianças, idosos e pacientes imunocomprometidos. Não é deixar de ter os animais, é entender os riscos para que a gente possa mitigá-los”, explicou a professora.
Elaine considera importante compreender o conceito de Saúde Única. “Como todos habitam o mesmo planeta, o que afeta um, afeta o outro. Por este motivo, médicos, médicos veterinários, biólogos, enfermeiros precisam atuar de maneira conjunta para não ficar compartimentalizado em uma única espécie.”

NÚMEROS IMPRESSIONANTES
No entanto, ainda estamos longe dessa realidade. Uma outra pesquisa realizada pela UFLA – da mestranda e médica veterinária Ana Carolina Chalfun de Santana, coorientada por Elaine e pela professora Carine Rodrigues Pereira – aponta que os produtores de leite têm feito uso indiscriminado de antimicrobianos nos animais. Minas Gerais é o principal produtor de leite do país, respondendo hoje por 27% do total extraído no Brasil.
Durante 12 meses, a equipe de pesquisa acompanhou 118 propriedades produtoras de leite no estado, de pequenas, com menos de 200 litros diários, a grandes, com mais de 3 mil litros diários. A quantidade de embalagens de antibiótico intramamário que foi recuperado dessas fazendas gira em torno de 48 mil frascos. “É um número muito grande, ficamos impressionados com a quantidade”, afirmou Elaine.
“Nós mapeamos que em torno de 70% a 85% do antimicrobiano que os produtores rurais usam são para tratar a mastite, que é a infecções da glândula mamária da vaca. A melhor notícia é que esse tipo de infecção, em torno de 35% das vezes, não se beneficia de tratamento com antimicrobiano. Então, o produtor rural está gastando dinheiro, assumindo o potencial de deixar resíduo de antimicrobiano no leite sem necessidade, descartando esse leite com resíduo, porque ele também paga pelo leite descartado, sem necessidade”, explicou a pesquisadora.
Ela conta que a pesquisa mostrou como, quando e para quê os produtores usam esses antimicrobianos. Por exemplo, em torno de 40% desse medicamento é utilizado no tratamento preventivo da mastite. Agora, a par da dimensão do problema, foi dado o primeiro passo para desenhar políticas públicas e estratégias para aprimorar o uso desses medicamentos.
PROJETOS DE EXTENSÃO
A UFLA mantém projetos de extensão para melhorar a qualidade do leite em 10 propriedades rurais de São Sebastião da Vitória, distrito de São João del Rei. A redução do uso de antimicrobianos é um dos caminhos. “Grande parte das mastites que acometem as vacas são causadas por micro-organismos gram-negativos. Em parte desses, especialmente o Escherichia coli, o animal consegue resolver a infecção sozinho, não precisando de tratamento. Se eu implementar essa cultura na fazenda, posso ir acompanhando a sintomatologia do animal, geralmente aumentando o número de ordenhas e com 24 horas ele já melhorou. Muitas vezes é necessário aplicar somente, quando necessário, anti-inflamatório”, explicou a pesquisadora.
Estudos mostram que, nesses casos, não faz diferença aplicar antibiótico intramamário. O produtor gasta, descarta o leite e o tratamento não está fazendo diferença. O antimicrobiano também é usado para prevenir novas infecções. Assim, quando uma lactação está terminando, o produtor aplica antibiótico na glândula mamária da vaca para evitar que na próxima lactação ela tenha mastite.
“Isso não é necessário para todas as vacas. A gente sabe que esses animais que não tiveram nenhum episódio de mastite durante a lactação anterior, e que têm uma baixa contagem de células somáticas na secagem, não precisam ser tratados preventivamente. Esse tratamento pode custar de R$ 50 a R$ 200 por vaca, um custo muito alto para o produtor”, alertou Elaine.
CONTAMINAÇÃO NO LEITE
O estudo sobre o uso de antimicrobianos na produção de leite ainda coletou amostras de tanque do leite nessas propriedades. Os pesquisadores isolaram micro-organismos que causam mastite nas vacas para avaliar se são resistentes a antimicrobianos. Esse também foi um resultado alarmante. Desses micro-organismos, menos de 5% foi sensível a tudo, enquanto cerca de 40% foi resistente a pelo menos três classes de drogas.
A partir desses resultados, a UFLA já aprovou outro projeto para entender se esse uso desenfreado de antimicrobianos está contaminando o leite. “Nós desenhamos um projeto que vai mapear a frequência com que o leite chega na plataforma contaminado com algum resíduo de produto veterinário. Nós não vamos pesquisar só antimicrobiano, nós vamos pesquisar também antiparasitários, como carrapaticidas que são usados. A gente quer entender se e com que frequência o leite chega contaminado por esses resíduos antibióticos na plataforma da indústria para ser processado, indo depois para a mesa do consumidor”, disse Elaine. O objetivo também é validar métodos para serem aplicados na rotina da indústria que possam identificar esse leite que tem resíduo.
Siga nosso canal no WhatsApp e receba notícias relevantes para o seu dia
Essa pesquisa deve começar neste mês de fevereiro ou em março. “Eu acho importante destacar que os projetos são financiados pela Fundação de Amparo à Pesquisa do Estado de Minas Gerais (Fapemig) e ambos ilustram a importância da parceria público-privada com instituições que têm excelência em pesquisa com quem está no campo no dia a dia, que são as cooperativas, os produtores rurais, que estão captando esse leite. Trabalhando de maneira multidisciplinar, trazendo o que cada um tem de melhor, a gente consegue avançar e trazer resultados significativos para a cadeia do leite que é tão importante para Minas Gerais”, ressaltou a pesquisadora.
